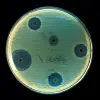

Teen fitness reduces risk of adulthood suicides
A study covering over a million Swedish men chalks up another reason why young people should be physically active.
The study covers all Swedish men born from 1950 to 1987 who participated in compulsory military service.
Researchers at the Sahlgrenska Academy in Gothenburg compared results of physical fitness tests among young conscripts with data in Sweden’s National Patient Register.
Their research indicates that poor cardiovascular fitness at age 18 links to a bigger risk of attempted suicide in adulthood.
The risk was almost doubled in comparison with the young men who were in good shape. The increase in risk can be observed year by year to over 40 years later.
The researchers could adjust for environmental and genetic factors through analysis of the 340,000 brothers included in the large longitudinal cohort group.
Maria Åberg, a researcher at the Sahlgrenska Academy, led the study. She points out that physical exercise has an impact on brain function.
“Physical exercise affects the plasticity of the brain by improving mental performance and increasing mental well-being,” says Åberg.
Excercise can also augment rehabilitation after certain mental illness and it has a preventive effect by helping protect nerve tissue.
Studies of child of adolescent health have shown that teenagers and young adults in Sweden feel less mentally fit than their contemporaries in other Western countries.
Research aimed at intervening in this trend is being ratcheted up with the goal of isolating factors that can prevent mental illness and lower the risk of suicide.
Critical period in brain development
It’s clear that depression is the most common cause of attempted and consummated suicides when we are older, but the picture is more complex, involving other factors, when it comes to young people.
Åberg points out that adolescence is a very critical period in the brain’s development.
“This is when emotional and social functions and practical capabilities mature,” says the researcher.
In an earlier study, Åberg’s research group showed that being physically fit as a teenager also has an effect on IQ and scholastic performance, and she thinks schools should give sports and PE higher status and more resources.
“Physical exercise should be evaluated in projects aimed at suicide prevention among young people,” says Åberg.
“Our results clearly indicate that school curriculums should include sports activities and encourage habits that promote and maintain physical fitness.”
------------------------------
Read the Norwegian version of this article at forskning.no
Translated by: Glenn Ostling